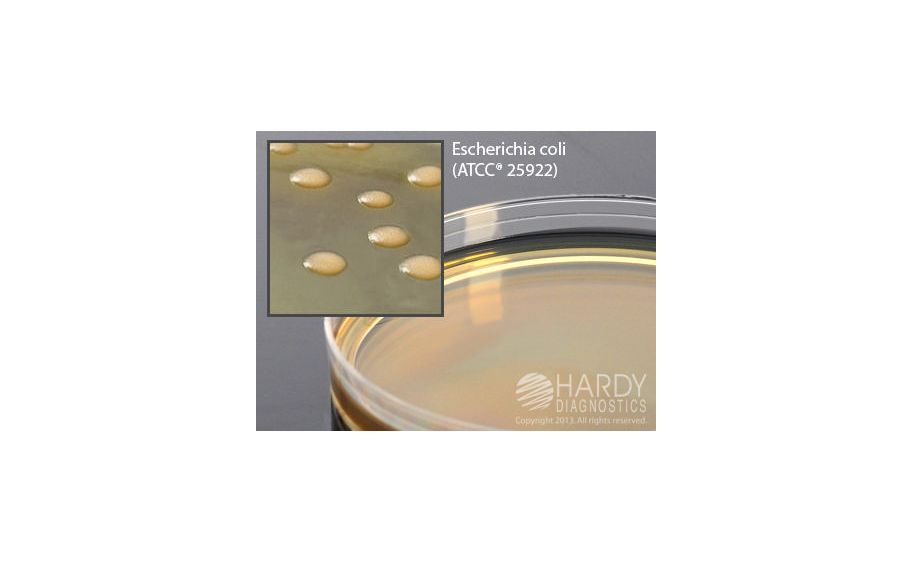
main product photo

Need Help?
800-229-7252

MANNITOL YEP AGAR PK10
1
/
PK
Lead Time
12 Day(s)
SKU
VWR10789-386-PK
MFRPN
G39
MANNITOL YEP AGAR PK10
Medium Mannitol YEP (Yeast Extract Peptone) Agar, pH 6.2, 15x100mm plate, 20ml fill, For use in the cultivation and enumeration of microorganisms and growth promotion testing for aloe products.
| Manufacturer | Hardy Diagnostics |
|---|---|
| MFRPN | G39 |
| Lead Time | 12 Day(s) |
| UNSPSC Code | 41100000 |
| Discipline | Life Science, Microbiology |
Write Your Own Review